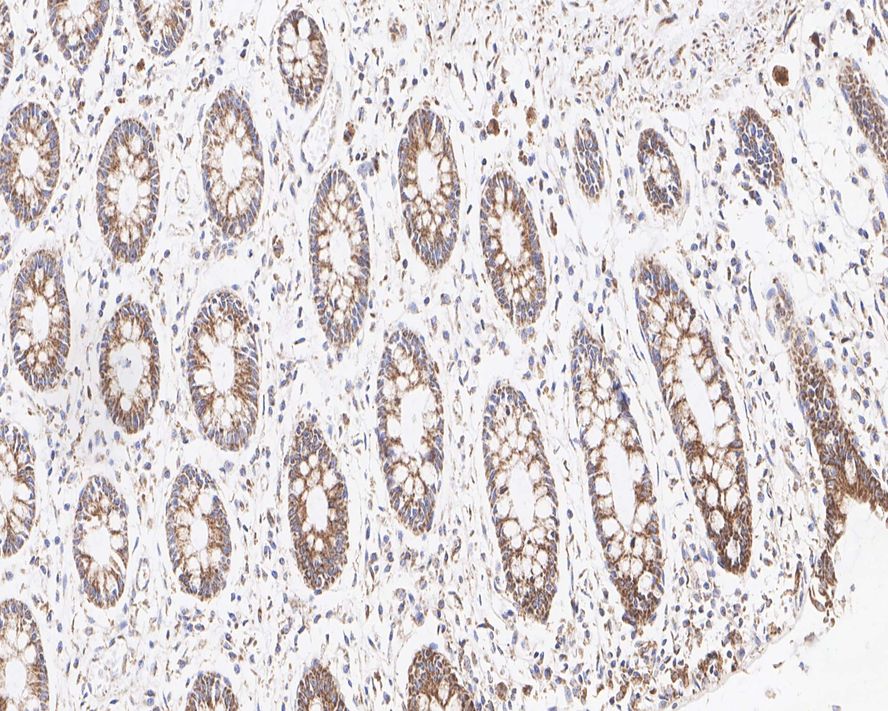

MAVS Recombinant Rabbit Monoclonal Antibody [PSH01-65] - BSA and Azide free
Catalog# HA750741
MAVS Recombinant Rabbit Monoclonal Antibody [PSH01-65] - BSA and Azide free
Application
-
WB
-
IHC-P
-
IF-Cell
-
IF-Tissue
Reactivity
-
Human